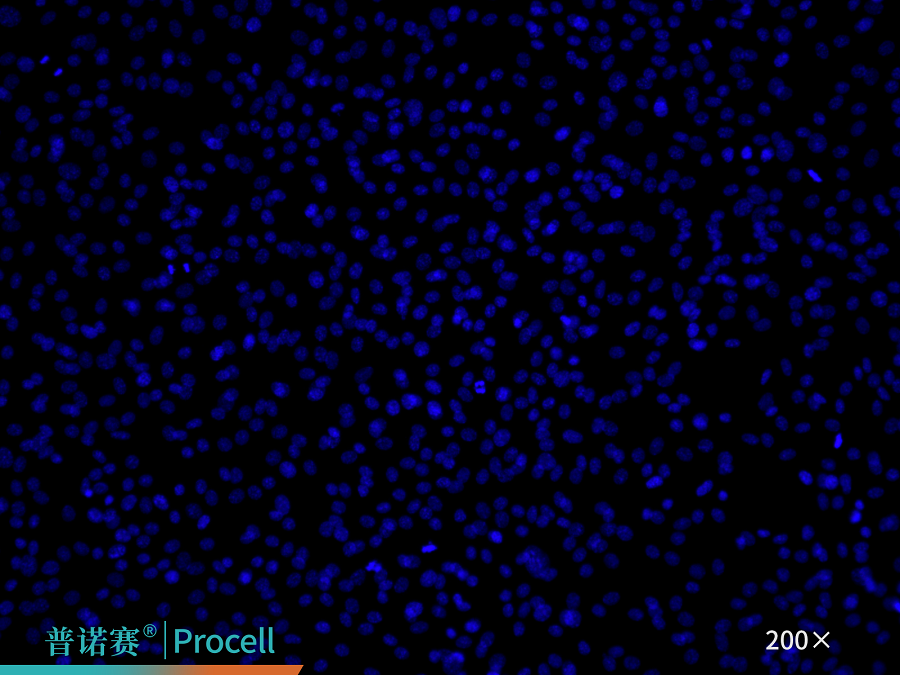
CD31免疫荧光鉴定

武汉普诺赛生命科技有限公司品牌商
13 年
手机商铺
- NaN
- 0.2999999999999998
- 0.2999999999999998
- 2.3
- 2.3
公司新闻/正文
实战:大鼠肺大动脉内皮细胞分离培养实操攻略!
209 人阅读发布时间:2026-03-19 09:28
肺大动脉作为连接右心室与肺循环的核心血管,其内皮细胞因直接承受来自右心室的高压血流及高剪切力,成为研究心肺血管类疾病的重要模型细胞。然而,这类细胞数量有限,且与平滑肌细胞等紧密相邻,分离过程极易出现细胞混杂的现象,影响实验结果的准确性。
本期细胞学堂以大鼠肺大动脉内皮细胞的分离为例,系统梳理关键操作步骤,助力科研人员高效、规范地制备肺大动脉内皮细胞,为相关研究的顺利开展提供支持。
一、基本信息
细胞名称:大鼠肺大动脉内皮细胞
组织来源:肺大动脉
细胞简介:肺大动脉(亦称肺动脉干)位于心包内,是一条粗短的动脉干,起于右心室流出道,位于主动脉弓前面。在主动脉弓下方分为左、右肺动脉,经肺门入肺。其主要功能是将脱氧血从心脏输送到肺部进行氧合。肺大动脉内皮细胞是血管内壁的主要组成细胞之一,在维持血管内外的动态平衡、合成和分泌细胞因子和介质、调控凝血和纤溶动态平衡中起重要作用。
形态特征:贴壁生长后呈单层多角形“铺路石样”分布,细胞边界清晰、形态均一。
二、分离流程
1、解剖操作
-
选用20-30日龄的Wistar、SD等品系大鼠,用戊ba比妥钠过量注射麻醉处死动物后,消毒仰卧固定。
-
剪开胸部皮肤并暴露胸骨,打开胸腔,去除胸腺,轻提心房,显露肺大动脉与主动脉弓。
-
自血管顶端略偏左向下剪下包含肺大动脉的组织(含心脏、主动脉弓及少量肺组织)(图1)。
2、组织处理
-
用大鼠肺大动脉内皮细胞专用清洗液反复清洗组织,去除血污。
-
剪去心脏底端1/2部位,挤压血管以清理内部凝结的血块,之后再次清洗(图2)。
-
去除主动脉弓与肺大动脉血管之间的脂肪,找到肺大动脉分支血管(图3),并剥离。
-
沿血管根部连接心脏的位置剪下,得到主动脉弓与肺大动脉组织(图4),进一步清理脂肪组织。
-
将主动脉弓与肺大动脉血管剪开(图5),留取纯净的肺大动脉组织,并将其纵向剖开(图6)。
 |
 |
| 图1. 剪下包含肺大动脉血管的一团组织 | 图2. 清理完血污的组织团 |
 |
 |
| 图3. 找到肺大动脉用显微直镊夹住 | 图4. 剪下的主动脉与肺大动脉 |
 |
 |
| 图5. 用显微剪将两根血管剪开 | 图6. 纵向剖开肺大动脉 |
3、组织消化
-
将处理好的肺大动脉组织放入专用消化液中,于37℃、5% CO2培养箱中消化30 min。
-
消化完成后,加入专用清洗液,吹打悬液约30次,使附着的内皮细胞分散到悬液中,收集悬液。
4、细胞分离
-
将收集的悬液通过100 μm细胞滤网进行过滤,收集滤液于离心管,1,200 rpm离心5 min,弃上清,保留沉淀。
5、细胞培养
-
培养器皿包被:将1 mL大鼠肺大动脉内皮细胞铺板工作液加入6 cm皿中,于37℃,5% CO2条件下孵育0.5-2 h。
-
细胞接种:细胞用大鼠肺大动脉内皮细胞完全培养基重悬后,接种于包被好的培养器皿中,于37℃,5% CO2条件下培养。
-
换液与传代:首次换液在48 h后进行,以后每2-3天换液一次,待细胞汇合度达到80-90%即可开始传代。
想了解更详细步骤,请查看大鼠肺大动脉内皮细胞分离培养试剂盒说明书。
三、细胞鉴定
1、形态鉴定
细胞呈“铺路石样”形态,符合内皮细胞典型形态特征。
2、标志物鉴定
采用CD31免疫荧光鉴定,细胞纯度可达90%以上(图7)。
 |
|
 |
| DAPI | CD31 | Merge |
图7. 大鼠肺大动脉内皮细胞免疫荧光鉴定
四、培养信息
换液频率:PLL(0.1 mg/mL)或明胶(0.1%)
培养基:大鼠肺大动脉内皮细胞完全培养基(含FBS、生长添加剂、Penicillin、Streptomycin等)
换液频率:每2-3天换液一次
生长特性:贴壁
细胞形态:内皮细胞样
传代比例:1:2
传代特性:可传2-3代
消化液:0.25%胰蛋白酶
五、应用方向
在肺血管疾病研究中,肺大动脉内皮细胞常被用于研究细胞增殖/凋亡失衡、线粒体动力学、内皮-间质转化、炎症反应、胞外囊泡介导的细胞间通讯,及基因/非编码RNA的功能验证等。
-
实例1:在人肺大动脉内皮细胞缺氧模型中,Hpgd(羟基前列腺素脱氢酶)在不同缺氧时长中均呈下降趋势。Hpgd可通过调节低氧处理的肺大动脉内皮细胞的增殖、凋亡、粘附性和血管生成能力,从而调节血管重构,参与低氧性肺动脉高压的发生和发展[1]。
-
实例2:用小鼠肺大动脉内皮细胞构建缺氧细胞模型,以探究circKrt4在低氧性肺动脉高压中的作用。结果显示,circKrt4通过双重机制促进疾病发生:一方面与Pura结合,驱动内皮-间质转化并增强 N-钙黏蛋白表达;另一方面抑制Glpk的线粒体转运,造成线粒体功能障碍。circKrt4通过协同调控Pura和Glpk,加剧肺大动脉内皮细胞损伤并推动疾病进展[2]。
以上是大鼠肺大动脉内皮细胞分离培养的全流程干货拆解,精准破解血管剥离、纯度把控等实验痛点~
更多原代细胞培养的核心技巧与实验方案,请持续关注细胞学堂专栏!
相关产品推荐:
| 货号 | 产品名称 | 规格 |
| CM-R011 | 大鼠肺大动脉内皮细胞完全培养基 | 100mL/125mLx4 |
| P-CA-608 | 大鼠肺大动脉内皮细胞分离培养试剂盒 | 3Tests/10Tests |
| PB180523 | 多聚-L-赖氨酸溶液 | 10mL |
| PB180535 | 明胶包被液 | 10mL |
| PB180225 | 0.25%胰蛋白酶溶液(含EDTA,溶于PBS) | 125mL/500mL |
| P-CA-607 | 大鼠主动脉平滑肌细胞分离培养试剂盒 | 3Tests / 10Tests |
| P-CA-606 | 大鼠主动脉内皮细胞分离培养试剂盒 | 3Tests / 10Tests |
| P-CA-610 | 大鼠大隐静脉平滑肌细胞分离培养试剂盒 | 3Tests / 10Tests |
| P-CA-611 | 大鼠脑动脉血管平滑肌细胞分离培养试剂盒 | 3Tests / 10Tests |
| CM-ZY007 | 平滑肌细胞完全培养基(适用于小鼠) | 500mL |
| CM-ZY006 | 平滑肌细胞完全培养基(适用于人和大鼠) | 500mL |
参考文献:
[1] He M, Tao K, Xiang M, Sun J. Hpgd affects the progression of hypoxic pulmonary hypertension by regulating vascular remodeling. BMC Pulmonary Medicine. 2023 Apr 13; 23 (1): 116.
[2] Qingjiao Chen, Mingui Chen, Jizhen Wang. Prognostic genes related to mitochondrial dynamics and mitophagy in diffuse large B-cell lymphoma are identified and validated using an integrated analysis of bulk and single-cell RNA sequencing, Frontiers in Imeunology, 2025(16).
[3] Ma C, Wang X, Zhang L. Super enhancer-associated circular RNA-circKrt4 regulates hypoxic pulmonary artery endothelial cell dysfunction in mice. Arteriosclerosis Thrombosis And Vascular Biology. 2023;43(7):1179-1198.
[4] Zhao L, Luo H, Li X. Exosomes derived from human pulmonary artery endothelial cells shift the balance between proliferation and apoptosis of smooth muscle cells. Cardiology. 2017; 137 (1): 43-53.






